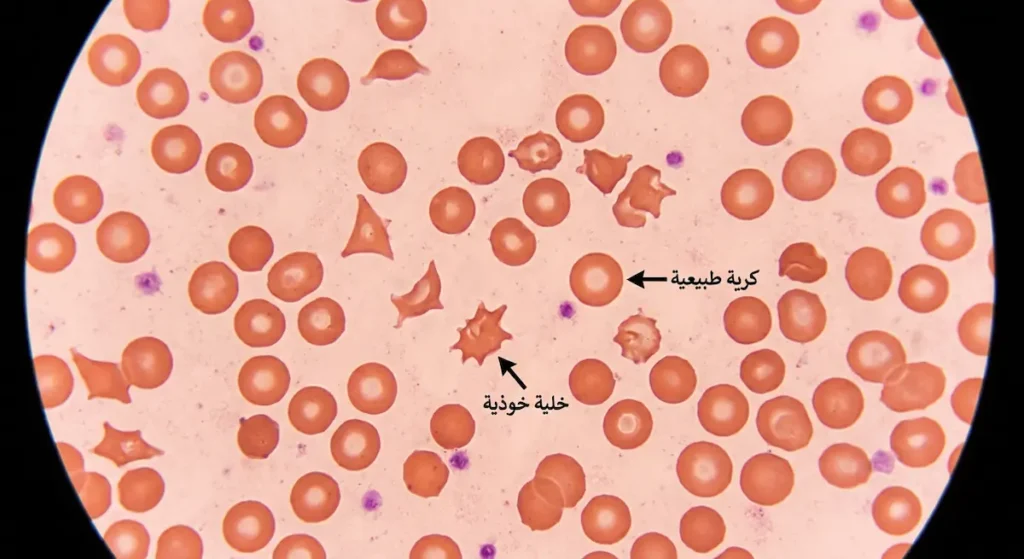
صورة مجهرية لمسحة دم تُظهر الخلايا الخوذية المتكسرة المميزة لمتلازمة انحلال الدم اليوريمية

متلازمة انحلال الدم اليوريمية: ما الذي يحدث حين تتحول عدوى بسيطة إلى تهديد للكلى؟
كيف تنتقل بكتيريا الطعام الملوث إلى تدمير خلايا الدم وإحداث الفشل الكلوي الحاد؟

متلازمة انحلال الدم اليوريمية هي حالة طبية خطيرة تتميز بثلاثي مرضي يشمل تكسر خلايا الدم الحمراء (فقر الدم الانحلالي)، ونقص الصفائح الدموية، والفشل الكلوي الحاد الذي يؤدي إلى تراكم اليوريا والسموم في الدم (Uremia). تصيب الأطفال دون سن الخامسة بشكل رئيس، وتنشأ غالباً بعد عدوى بكتيرية معوية ببكتيريا الإشريكية القولونية المنتجة لسموم الشيغا.
✅ المراجعة الطبية: د. زيد مراد — اختصاصي طب عام
✅ مراجعة التغذية: د. علا الأحمد — اختصاصية تغذية علاجية
✅ المراجعة الدوائية: جاسم محمد مراد — مستشار دوائي
📌 التحرير: هيئة التحرير العلمية — موسوعة خلية
📅 آخر تحديث: مارس 2026
لأي ملاحظة أو تصحيح: تواصل معنا
هل تخيلت يوماً أن وجبة همبرغر غير مطهوة جيداً قد تنتهي بطفلك في وحدة العناية المركزة؟ قد يبدو الأمر مبالغاً فيه، لكنه واقع طبي موثق. أنت كأب أو أم تقرأ هذه السطور ربما لأن طبيب طفلك ذكر أمامك مصطلح مرض HUS، أو ربما لأنك طالب طب تحاول فهم آلية هذا المرض المعقد. في كلتا الحالتين، ستجد هنا ما تبحث عنه بالضبط. لقد جمعنا في هذه المقالة أحدث المعلومات الطبية المدعومة بالمراجع العلمية، مع شرح مبسط للآلية المرضية وطرق العلاج والوقاية، لتكون مرجعاً متكاملاً يغنيك عن عشرات الصفحات المتفرقة.
⚡ خلاصة المقال في دقيقة واحدة
🔴 حقائق جوهرية
- متلازمة انحلال الدم اليوريمية ثلاثية مرضية: تكسر كريات الدم + نقص الصفائح + فشل كلوي حاد.
- السبب الأشهر: بكتيريا E. coli O157:H7 من اللحوم غير المطهوة جيداً.
- النوع النمطي يشكل 90% من الحالات ويصيب الأطفال دون 5 سنوات.
- نسبة الشفاء تتجاوز 90% مع التدخل الطبي المبكر.
🛡️ خطوات وقائية فورية
- اطهُ اللحم المفروم لدرجة حرارة داخلية لا تقل عن 70°C.
- اغسل الخضروات والفواكه بالماء الجاري 30 ثانية على الأقل.
- تجنب الحليب غير المبستر ومياه الشرب غير المعالجة.
- علّم أطفالك غسل اليدين بالصابون 20 ثانية بعد الحمام وقبل الأكل.
⚠️ تحذيرات طبية حاسمة
- لا تُعطِ طفلك مضادات حيوية أو مضادات إسهال عند إسهال مدمم دون استشارة طبيب — قد تزيد الخطر.
- الإسهال المدمم عند الأطفال يستوجب زيارة الطوارئ فوراً وليس الانتظار.
- 30% من المتعافين يعانون مشاكل كلوية مزمنة لاحقاً — المتابعة بعد الشفاء ضرورية لسنوات.
ما هي متلازمة انحلال الدم اليوريمية (HUS) ولماذا تحمل هذا الاسم؟
اسم هذه المتلازمة يختصر قصتها كاملة. كلمة “انحلال الدم” (Hemolysis) تعني تكسر كريات الدم الحمراء بشكل غير طبيعي. أما “اليوريمية” فتشير إلى حالة Uremia، وهي تراكم مادة اليوريا (Urea) والسموم النيتروجينية الأخرى في مجرى الدم نتيجة عجز الكلى عن تصفيتها. فحين نجمع بين هذين المصطلحين، نحصل على صورة واضحة لمتلازمة تجمع بين تدمير خلايا الدم وفشل وظائف الكلى في آن واحد.
وُصفت هذه الحالة لأول مرة عام 1955 من قبل الطبيب السويسري كونراد غاسر (Conrad Gasser) وزملائه، حين لاحظوا مجموعة من الأطفال يعانون من فقر دم انحلالي حاد مصحوب بفشل كلوي. ومنذ ذلك الحين، أصبحت متلازمة انحلال الدم اليوريمية من أبرز أسباب الفشل الكلوي الحاد عند الأطفال الصغار حول العالم.
اقرأ أيضاً: علم الأمراض (Pathology): دراسة الأمراض وتأثيرها على الجسم
📌 معلومة سريعة
وفقاً لمراكز السيطرة على الأمراض والوقاية منها (CDC)، تُسجَّل في الولايات المتحدة وحدها نحو 500 حالة إصابة بمتلازمة انحلال الدم اليوريمية النمطية سنوياً، معظمها عند أطفال تقل أعمارهم عن 5 سنوات.
ما العلاقة بين مصطلح “اليوريميا” ومتلازمة HUS؟
كثيراً ما يحدث خلط بين المتلازمة نفسها وبين عَرَض اليوريميا. لذا دعونا نوضح الفرق بدقة. اليوريميا وتسمم الدم بالسموم الكلوية ليست مرضاً قائماً بذاته، بل هي نتيجة نهائية لأي سبب يؤدي إلى فشل الكلى في أداء وظيفتها الترشيحية. حين تتوقف الكلى عن تصفية الدم، تتراكم مواد مثل اليوريا والكرياتينين وحمض اليوريك في الجسم، مسببة أعراضاً خطيرة كالغثيان والتشوش الذهني والتشنجات.
في سياق متلازمة انحلال الدم اليوريمية، تحدث اليوريميا كحلقة أخيرة في سلسلة مرضية تبدأ بعدوى بكتيرية. فالسموم البكتيرية تُتلف الأوعية الدموية الدقيقة في الكلى، مما يعطل قدرتها على الترشيح. وبالتالي فإن الفرق بين متلازمة انحلال الدم واليوريميا يكمن في أن المتلازمة هي “السبب” بينما اليوريميا هي “النتيجة”. فهم هذه العلاقة ضروري لإدراك خطورة المرض ولماذا يستوجب تدخلاً طبياً عاجلاً.
اقرأ أيضاً: علم وظائف الأعضاء (Physiology): استكشاف آليات الحياة
ماذا يحدث داخل الجسم حقاً عند الإصابة؟
الآلية المرضية خطوة بخطوة

تصور أن الأوعية الدموية الدقيقة في كليتيك هي أنابيب رفيعة جداً مبطنة بطبقة ناعمة من الخلايا البطانية (Endothelial Cells). هذه البطانة هي خط الدفاع الأول. حين تدخل سموم الشيغا (Shiga Toxin) التي تنتجها بكتيريا الإشريكية القولونية إلى مجرى الدم، فإنها تستهدف هذه البطانة تحديداً وتدمرها.
ما الذي يحدث بعد ذلك؟ حين تتضرر البطانة الوعائية، يستجيب الجسم كما يفعل عادة مع أي جرح: يبدأ بتكوين جلطات دموية صغيرة جداً تُعرف بالجلطات الدقيقة (Microthrombi). لكن المشكلة أن هذه الجلطات تتكون داخل الأوعية الدموية الصغيرة للكلى وليس على سطح جرح خارجي. تخيل أن هذه الجلطات تسد الأنابيب الدقيقة جزئياً، فتصبح الممرات ضيقة ومشوهة.
الآن تأتي المرحلة المأساوية: كريات الدم الحمراء التي تمر عبر هذه الممرات الضيقة والمليئة بالجلطات تتعرض لقوى ميكانيكية تمزقها حرفياً. هذا التمزق يُسمى “انحلال الدم الميكانيكي” (Mechanical Hemolysis)، وينتج عنه ما يُعرف بكريات الدم الحمراء المشوهة أو “الخلايا الخوذية” (Schistocytes) التي يراها المختبر تحت المجهر. بالإضافة إلى ذلك، تُستهلك الصفائح الدموية (Platelets) في عملية تكوين تلك الجلطات الدقيقة، فينخفض عددها بشكل حاد في الدم.
“أنصح كل أم لاحظت إسهالاً مدمماً عند طفلها بعد تناول لحوم مشكوك في طهيها ألا تتأخر في مراجعة الطوارئ، حتى لو بدا الطفل نشيطاً في البداية. التدخل خلال الساعات الأولى قد يمنع تطور الحالة إلى فشل كلوي حاد ويوريميا.”
— الدكتور زيد مراد، اختصاصي طب عام
وعليه فإن النتيجة النهائية لهذه السلسلة المرضية هي ثلاثية مدمرة: فقر دم انحلالي (بسبب تكسر الكريات)، ونقص صفائح دموية (بسبب استهلاكها في الجلطات)، وفشل كلوي حاد (بسبب انسداد الأوعية الكلوية وتلف بطانتها). هذه الثلاثية هي ما يُعرف طبياً بمرض HUS.

اقرأ أيضاً: الإنتان (Sepsis): الأسباب، الأعراض، والعلاج
🔬 حقيقة طبية مدهشة
سموم الشيغا لا تُتلف خلايا الكلى فحسب، بل ترتبط بمستقبل محدد يُسمى (Gb3 – Globotriaosylceramide) الموجود بكثافة على سطح خلايا الكلى والأمعاء والدماغ، وهذا يفسر لماذا تتأثر هذه الأعضاء تحديداً دون غيرها.
المصدر: The Lancet — Shiga-toxin-producing E. coli and HUS (2005)
ما هي أنواع متلازمة انحلال الدم اليوريمية؟

النوع النمطي (Typical HUS – D+HUS)
هذا النوع هو الأكثر شيوعاً ويُشكل نحو 90% من جميع الحالات. يرتبط ارتباطاً مباشراً بالعدوى المعوية، وتحديداً ببكتيريا الإشريكية القولونية من السلالة O157:H7 المنتجة لسموم الشيغا (STEC). يُطلق عليه أيضاً (D+HUS) لأنه يسبقه إسهال (Diarrhea). يصيب الأطفال دون سن الخامسة بشكل رئيس، وغالباً ما يبدأ بعد 5 إلى 10 أيام من التعرض للعدوى البكتيرية.
المسار النموذجي يبدأ بتناول طعام ملوث (لحم مفروم غير مطهو جيداً، حليب غير مبستر، خضروات ملوثة)، يتبعه إسهال مائي يتحول إلى مدمم خلال أيام. ثم تظهر علامات انحلال الدم والفشل الكلوي. لقد أظهرت البيانات الوبائية أن هذا النوع يميل إلى الحدوث في فصل الصيف وأوائل الخريف حين تنشط البكتيريا في البيئة.
النوع غير النمطي (Atypical HUS – aHUS)
على النقيض من ذلك، فإن متلازمة انحلال الدم اليوريمية غير النمطية لا ترتبط بعدوى بكتيرية معوية. سببها خلل وراثي في جهاز المناعة التكميلي (Complement System)، وهو جزء من المناعة الفطرية يُفترض أن يحمي الجسم. لكن حين تحدث طفرات جينية في البروتينات المنظمة لهذا الجهاز (مثل العامل H أو العامل I أو بروتين MCP)، يصبح الجهاز التكميلي نشطاً بشكل مفرط ويهاجم خلايا الجسم نفسه.
هذا النوع نادر ويُشكل نحو 5-10% من الحالات فقط. لكنه أشد خطورة بكثير. إذ يصيب البالغين والأطفال على حد سواء، ومعدل الوفاة أو الوصول إلى الفشل الكلوي المزمن فيه أعلى بكثير. أثبتت دراسة منشورة في مجلة The New England Journal of Medicine عام 2009 أن نحو 50% من مرضى aHUS يصلون إلى مرحلة الفشل الكلوي النهائي أو الوفاة خلال السنة الأولى من التشخيص إن لم يُعالَجوا بالأدوية المناعية الحديثة.
ما هي متلازمة انحلال الدم اليوريمية غير النمطية في جوهرها إذاً؟ هي اضطراب مناعي وراثي يحاكي أعراض النوع النمطي لكن بآلية مختلفة تماماً، وهذا التمييز حاسم لأن العلاج يختلف جذرياً بين النوعين.
“الفهم الدقيق للطفرات الجينية في الجهاز التكميلي أحدث تحولاً جذرياً في تشخيص وعلاج متلازمة انحلال الدم اليوريمية غير النمطية. لم يعد التشخيص يعتمد على الاستبعاد فقط، بل أصبح لدينا أدوات جينية دقيقة تحدد الطفرة وتوجه خيار العلاج المناسب لكل مريض.”
— البروفيسور مارينا نوريس (Marina Noris, PhD)، معهد ماريو نيغري للأبحاث الدوائية، بيرغامو، إيطاليا
اقرأ أيضاً: علم المناعة (Immunology): الجهاز المناعي والأمراض
جدول (1): مقارنة شاملة بين النوع النمطي والنوع غير النمطي من متلازمة انحلال الدم اليوريمية
| وجه المقارنة | النوع النمطي (Typical HUS) | النوع غير النمطي (Atypical HUS – aHUS) |
|---|---|---|
| نسبة الشيوع | 90% من الحالات | 5 – 10% من الحالات |
| السبب الرئيس | عدوى بكتيرية (E. coli O157:H7) منتجة لسموم الشيغا | طفرات جينية في منظمات الجهاز التكميلي (Complement System) |
| الفئة العمرية الأكثر إصابة | الأطفال دون سن 5 سنوات | جميع الأعمار (بما فيها البالغون) |
| وجود إسهال مسبق | نعم — إسهال مدمم دائماً (D+HUS) | لا — غالباً بدون إسهال مسبق |
| نسبة الشفاء التام | أكثر من 90% مع العلاج الداعم | 50% يصلون للفشل الكلوي النهائي بدون علاج مناعي |
| نسبة الوفاة | 2 – 5% | تصل إلى 25% بدون علاج موجّه |
| العلاج الأساسي | علاج داعم (سوائل، نقل دم، غسيل كلى مؤقت) | إيكوليزوماب (Eculizumab) أو رافوليزوماب (Ravulizumab) |
| خطر الانتكاس | نادر جداً | مرتفع — قد يتكرر عند إيقاف العلاج |
| الموسمية | الصيف وأوائل الخريف | لا يرتبط بموسم محدد |
| المصادر: The Lancet — Haemolytic uraemic syndrome (2017) | New England Journal of Medicine — Atypical HUS (2009) | CDC — E. coli General Information | ||
ما هي الأسباب وعوامل الخطر الحقيقية وراء المرض؟
فهم أسباب انحلال الدم اليوريمية يبدأ من المطبخ وينتهي في الجينات. دعونا نستعرض العوامل المختلفة بشكل منظم:
- العدوى البكتيرية: بكتيريا الإشريكية القولونية (E. coli O157:H7) هي المسبب الأول والأشهر. كما أن بكتيريا الشيغيلا (Shigella dysenteriae) يمكنها إنتاج سموم شيغا مشابهة. وفي حالات أقل شيوعاً، ارتبطت بكتيريا السالمونيلا وبعض أنواع العقديات الرئوية (Streptococcus pneumoniae) بحدوث المتلازمة.
- الطفرات الجينية: في حالة aHUS، تُعَدُّ الطفرات في جينات منظمات الجهاز التكميلي (مثل CFH, CFI, MCP, CFB, C3) السبب الجذري. هذه الطفرات قد تكون موروثة أو قد تحدث بشكل عفوي.
- الأدوية: بعض أدوية العلاج الكيميائي مثل ميتومايسين C (Mitomycin C) وأدوية مثبطات الكالسينورين (Calcineurin Inhibitors) المستخدمة بعد زراعة الأعضاء قد تُحفز حدوث المتلازمة.
- الحمل وما بعد الولادة: تُعَدُّ فترة ما بعد الولادة من العوامل المحفزة لظهور aHUS عند النساء الحاملات لطفرات جينية كامنة.
- أمراض المناعة الذاتية: مثل الذئبة الحمراء (SLE) ومتلازمة أضداد الفوسفولبيد.
“إن الوقاية من متلازمة انحلال الدم اليوريمية تبدأ من سلامة الغذاء وليس من غرفة الطوارئ. الطهي الجيد للحوم المفرومة وحده قادر على منع معظم حالات الإصابة عند الأطفال. ويجب على الأطباء تجنب وصف المضادات الحيوية في حالات الاشتباه بعدوى E. coli O157:H7.”
— البروفيسور فيليب تار (Phillip I. Tarr, MD)، كلية الطب بجامعة واشنطن، سانت لويس، الولايات المتحدة
من هم الفئات الأكثر عرضة للإصابة؟ الأطفال دون سن الخامسة يتصدرون القائمة للنوع النمطي. كبار السن فوق 65 عاماً معرضون أيضاً لمضاعفات أشد. كما أن ذوي المناعة الضعيفة ومرضى الزراعة يواجهون خطراً مضاعفاً. وفي المملكة العربية السعودية، حيث ترتفع درجات الحرارة صيفاً وتزداد مخاطر التسمم الغذائي في المناسبات والولائم الكبيرة، يجب توخي الحذر الشديد في طهي اللحوم وحفظ الأطعمة.
اقرأ أيضاً: علم الوراثة (Genetics): المبادئ الأساسية وتطبيقاتها
❓ هل تعلم؟
في عام 2011، اجتاح وباء ضخم لبكتيريا E. coli O104:H4 ألمانيا وأوروبا، أصيب خلاله أكثر من 3,800 شخص بالعدوى، وتطور لدى نحو 850 منهم مرض HUS، وتوفي 54 شخصاً. كان هذا أكبر تفشٍّ موثق لمتلازمة انحلال الدم اليوريمية في التاريخ الحديث، وكان مصدره براعم الحلبة الملوثة.
المصدر: NEJM — Epidemic Profile of Shiga-Toxin-Producing E. coli O104:H4 (2011)
اقرأ أيضاً: التلوث الميكروبي: ما مصادره وكيف نحمي أنفسنا من أخطاره؟
ما هي الأعراض والمؤشرات التحذيرية في كل مرحلة؟
سيناريو من الواقع: قصة أحمد ذو الأربع سنوات
لنفهم أعراض متلازمة انحلال الدم بشكل عملي، تخيل هذا السيناريو الواقعي. أحمد طفل سعودي عمره 4 سنوات، تناول مع عائلته وجبة شواء في استراحة خلال عطلة نهاية الأسبوع. بعد ثلاثة أيام، بدأ يشكو من آلام في بطنه مع إسهال مائي. اعتقدت والدته أنه “برد في البطن” عادي وأعطته سوائل. لكن في اليوم الخامس، لاحظت دماً في البراز. نُقل إلى الطوارئ، وخلال يومين ظهر شحوب شديد في وجهه مع كدمات صغيرة على ساقيه. أظهرت التحاليل تكسراً في كريات الدم، ونقصاً حاداً في الصفائح، وارتفاعاً كبيراً في اليوريا والكرياتينين. شُخِّصت حالته بأنها متلازمة انحلال الدم اليوريمية.
مراحل تطور الأعراض

المرض لا يضرب دفعة واحدة بل يمر بمراحل واضحة:
المرحلة الأولى – المؤشرات الهضمية المبكرة (اليوم 1-5):
تبدأ الأعراض بما يشبه التسمم الغذائي العادي. إسهال مائي يتحول خلال يوم أو يومين إلى إسهال مدمم. آلام بطنية شديدة، خاصة في المنطقة حول السرة. تقيؤ متكرر قد يؤدي إلى جفاف. حمى خفيفة لا تتجاوز عادة 38.5 درجة مئوية. هذه المرحلة هي النافذة الذهبية للتدخل، لأن كثيراً من الأهالي يتجاهلون هذه الأعراض ظناً منهم أنها نزلة معوية عابرة.
المرحلة الثانية – مرحلة انحلال الدم (اليوم 5-10):
هنا يبدأ الجسم بالانهيار من الداخل. شحوب شديد ومفاجئ في الوجه والشفتين. إرهاق غير مبرر وخمول واضح. ظهور كدمات دقيقة تحت الجلد تُسمى الحبرات (Petechiae) بسبب نقص الصفائح. نزيف من الأنف أو اللثة دون سبب واضح. اصفرار خفيف في بياض العينين (اليرقان) بسبب تكسر كريات الدم وإطلاق البيليروبين.
المرحلة الثالثة – مرحلة الفشل الكلوي واليوريميا (بعد اليوم 7-14):
هذه المرحلة هي الأخطر. قلة التبول بشكل ملحوظ أو انعدامه تماماً (Oliguria/Anuria). تورم في الوجه والأطراف واليدين بسبب احتباس السوائل (الوذمة). ارتفاع ضغط الدم. تشوش ذهني وهياج أو نعاس مفرط. في الحالات الشديدة، قد تحدث تشنجات أو فقدان للوعي.
جدول (2): مراحل تطور أعراض متلازمة انحلال الدم اليوريمية والعلامات التحذيرية لكل مرحلة
| المرحلة | التوقيت | الأعراض الرئيسة | مستوى الخطورة |
|---|---|---|---|
| المرحلة الأولى (المؤشرات الهضمية) |
اليوم 1 – 5 | إسهال مائي يتحول إلى مدمم، آلام بطنية حول السرة، تقيؤ متكرر، حمى خفيفة (أقل من 38.5°C) | ⚠️ تحذيري — النافذة الذهبية للتدخل |
| المرحلة الثانية (انحلال الدم) |
اليوم 5 – 10 | شحوب شديد، إرهاق غير مبرر، كدمات دقيقة (Petechiae)، نزيف من الأنف أو اللثة، اصفرار خفيف في العينين | 🔴 مرتفع — يجب التوجه للطوارئ فوراً |
| المرحلة الثالثة (الفشل الكلوي واليوريميا) |
بعد اليوم 7 – 14 | قلة التبول أو انعدامه، تورم الوجه والأطراف (وذمة)، ارتفاع ضغط الدم، تشوش ذهني، تشنجات أو فقدان وعي | 🔴🔴 حرج — يستلزم عناية مركزة وغسيل كلى |
| المصادر: NIDDK — Hemolytic Uremic Syndrome in Children | Pediatric Nephrology — Treatment and Outcome of HUS (2008) | |||
⚡ نقطة تحول
من أخطر الأخطاء الشائعة عند إصابة الطفل بإسهال مدمم هو إعطاؤه مضادات حيوية دون استشارة طبية. أثبتت دراسة نُشرت في مجلة The New England Journal of Medicine عام 2000 أن استخدام المضادات الحيوية في عدوى E. coli O157:H7 قد يزيد فعلياً من خطر تطور الحالة إلى متلازمة انحلال الدم اليوريمية، لأن قتل البكتيريا يؤدي إلى تحرير كميات كبيرة من سموم الشيغا دفعة واحدة.
المصدر: NEJM — Risk of HUS after Antibiotic Treatment (2000)
لماذا يُعَدُّ التدخل السريع ضرورة حياة وليس رفاهية؟
مضاعفات انحلال الدم اليوريمي على الكلى هي الأكثر شيوعاً، لكنها ليست الوحيدة. الفشل الكلوي الحاد (Acute Kidney Failure) يحدث عند نحو 50-70% من المرضى ويستلزم غسيل كلى مؤقت. من ناحية أخرى، يعاني حوالي 25% من الناجين من مشاكل كلوية مزمنة على المدى البعيد، تشمل ارتفاع ضغط الدم المزمن وبيلة بروتينية مستمرة.
المضاعفات العصبية تُعَدُّ الأشد رعباً. إذ تشمل التشنجات والسكتات الدماغية والغيبوبة، وتحدث عند نحو 20-30% من الحالات. سموم الشيغا تستهدف الأوعية الدموية الدماغية كما تستهدف أوعية الكلى، مما يسبب اعتلالاً دماغياً قد يترك أثراً دائماً.
القلب والبنكرياس لا يسلمان أيضاً. التهاب عضلة القلب واعتلال القلب قد يحدثان في الحالات الشديدة. كما أن تلف البنكرياس قد يؤدي إلى داء السكري من النوع الأول عند بعض الأطفال الناجين. الأمعاء أيضاً قد تتعرض لنقص التروية الدموية مما يسبب انثقاباً معوياً يستلزم تدخلاً جراحياً طارئاً.
وفقاً لإحصائيات حديثة، تبلغ نسبة الوفاة في النوع النمطي من 2-5% مع العلاج المناسب. بينما ترتفع النسبة في النوع غير النمطي إلى 25% في غياب العلاج المناعي الموجه. من جهة ثانية، فإن نسبة الشفاء من متلازمة انحلال الدم اليوريمية النمطية تصل إلى أكثر من 90% عند الأطفال الذين يتلقون رعاية طبية مبكرة ومناسبة.
اقرأ أيضاً: أمراض القلب: ما الذي يجب أن تعرفه لحماية قلبك؟
📊 رقم صادم
أظهرت دراسة منشورة في مجلة Pediatric Nephrology عام 2019 أن نحو 30% من الأطفال الذين أصيبوا بمتلازمة انحلال الدم اليوريمية النمطية وتعافوا ظاهرياً عانوا لاحقاً من مشاكل كلوية مزمنة بعد 10 – 15 سنة من الإصابة الأولى، بما في ذلك بيلة بروتينية وارتفاع ضغط الدم. لذلك فإن المتابعة الطبية بعد الشفاء ليست اختيارية.
المصدر: Pediatric Nephrology — Long-term Outcomes of STEC-HUS (2019)
كيف يتم تشخيص المتلازمة بدقة في المختبر؟
التشخيص يعتمد على الجمع بين الصورة السريرية والفحوصات المختبرية. الطبيب يبحث عن الثلاثية المميزة: فقر الدم الانحلالي، نقص الصفائح، والفشل الكلوي.
الفحوصات المطلوبة تشمل:
- تحليل الدم الشامل (CBC): يُظهر انخفاض الهيموغلوبين (فقر دم) مع انخفاض عدد الصفائح الدموية. الجدير بالذكر أن رؤية الخلايا الخوذية (Schistocytes) في مسحة الدم المحيطية هي العلامة المختبرية الأبرز لتأكيد تكسر الدم الميكانيكي.
- اختبارات وظائف الكلى: ارتفاع اليوريا (Uremia) والكرياتينين (Creatinine) في الدم يؤكد تضرر الكلى. كلما ارتفعت هذه القيم، دل ذلك على شدة الإصابة الكلوية.
- اختبار كومبس المباشر (Direct Coombs Test): يكون سلبياً في HUS، وهذا يميزها عن أسباب تكسر الدم المناعية الأخرى. نتيجة سلبية مع وجود خلايا خوذية تقول بوضوح: “التكسر ميكانيكي وليس مناعياً”.
- مستوى اللاكتات ديهيدروجيناز (LDH): يرتفع بشكل كبير لأنه يُطلق من الخلايا المتكسرة.
- مستوى الهابتوغلوبين (Haptoglobin): ينخفض لأنه يُستهلك في الارتباط بالهيموغلوبين الحر الناتج عن تكسر الكريات.
- تحليل البول: يُظهر وجود بروتين (بيلة بروتينية) ودم (بيلة دموية).
- تحليل البراز: للكشف عن بكتيريا E. coli O157:H7 أو سمومها (Shiga Toxin) باستخدام اختبار الزراعة أو اختبار PCR السريع.
- الفحوصات الجينية وفحوصات الجهاز التكميلي: تُجرى عند الاشتباه بالنوع غير النمطي (aHUS)، وتشمل فحص مستويات C3 و C4 والعامل H والأجسام المضادة ضد العامل H.
جدول (3): الفحوصات المخبرية الأساسية لتشخيص متلازمة انحلال الدم اليوريمية ودلالة كل فحص
| الفحص | النتيجة المتوقعة في HUS | الدلالة السريرية |
|---|---|---|
| تحليل الدم الشامل (CBC) | انخفاض الهيموغلوبين + انخفاض الصفائح الدموية | فقر دم انحلالي + نقص صفائح |
| مسحة الدم المحيطية | وجود خلايا خوذية (Schistocytes) | تأكيد تكسر الدم الميكانيكي |
| اليوريا والكرياتينين | ارتفاع ملحوظ | فشل كلوي حاد ويوريميا (Uremia) |
| اختبار كومبس المباشر (Direct Coombs) | سلبي | يستبعد التكسر المناعي الذاتي |
| اللاكتات ديهيدروجيناز (LDH) | مرتفع جداً | علامة على تدمير الخلايا النشط |
| الهابتوغلوبين (Haptoglobin) | منخفض جداً أو غير قابل للقياس | مُستهلك في الارتباط بالهيموغلوبين الحر |
| تحليل البول | بروتين + دم | بيلة بروتينية وبيلة دموية — تلف كلوي |
| تحليل البراز (زراعة أو PCR) | إيجابي لسموم الشيغا أو E. coli O157:H7 | تأكيد السبب البكتيري (النوع النمطي) |
| فحوصات الجهاز التكميلي والجينية | طفرات في CFH, CFI, MCP أو انخفاض C3 | تأكيد النوع غير النمطي (aHUS) |
| المصادر: The Lancet — Haemolytic uraemic syndrome (2017) | Orphanet Journal of Rare Diseases — Atypical HUS (2011) | ||
في المملكة العربية السعودية، تتوفر معظم هذه الفحوصات في المستشفيات التخصصية الكبرى ومختبرات المراجع. لكن الفحوصات الجينية المتقدمة قد تحتاج إلى إرسال العينات لمختبرات متخصصة دولياً.
اقرأ أيضاً: طب الأطفال (Pediatrics): التخصص، الأمراض، والرعاية
ما هي بروتوكولات العلاج الحديثة المتبعة عالمياً؟
علاج انحلال الدم اليوريمي عند الأطفال والبالغين يعتمد على نوع المتلازمة وشدتها. لا يوجد “دواء سحري” واحد، بل منظومة علاجية متكاملة.
العلاج الداعم في المستشفى يُشكل حجر الأساس للنوع النمطي. تعويض السوائل والأملاح بدقة عبر الوريد أمر بالغ الأهمية، مع الحرص على عدم إرهاق الكلى المتضررة بكميات مفرطة. المعادلة هنا دقيقة: سوائل كافية للحفاظ على الترطيب، لكن ليس أكثر مما تستطيع الكلى التعامل معه. مراقبة ضغط الدم ومستويات الكهارل (الصوديوم والبوتاسيوم) على مدار الساعة ضرورية.
نقل الدم يُلجأ إليه حين ينخفض الهيموغلوبين إلى مستويات خطيرة (عادة أقل من 6-7 غ/دل). يتم نقل كريات دم حمراء مركزة ببطء لتجنب زيادة الحمل على القلب. بالمقابل، نقل الصفائح الدموية موضع جدل طبي كبير؛ إذ يعتقد كثير من الأطباء أن نقل الصفائح قد يُغذي عملية تكون الجلطات الدقيقة ويزيد الأمر سوءاً. لذلك لا تُنقل الصفائح إلا في حالات النزيف الحاد المهدد للحياة.
غسيل الكلى (Dialysis) يصبح ضرورياً حين تفشل الكلى في تصفية الدم من السموم وتتطور حالة الفشل الكلوي الحاد واليوريميا الشديدة. متى تحديداً؟ حين يرتفع البوتاسيوم إلى مستويات خطيرة (أعلى من 6.5 ملي مول/لتر)، أو حين يحدث احتباس شديد للسوائل مع وذمة رئوية، أو حين تظهر أعراض عصبية ناجمة عن تسمم الدم بالسموم الكلوية. الغسيل الكلوي في هذه الحالة مؤقت عادة وليس دائماً، لأن كلى الأطفال تمتلك قدرة استثنائية على التعافي.
“يجب التنبيه إلى أن استخدام الأدوية المضادة للإسهال مثل اللوبيراميد (Loperamide) ممنوع تماماً في حالات الإسهال المدمم المشتبه بإصابتها ببكتيريا E. coli، لأنها تبطئ حركة الأمعاء وتسمح بامتصاص كميات أكبر من السموم إلى مجرى الدم.”
دواء إيكوليزوماب (Eculizumab – Soliris): هذا الدواء أحدث ثورة في علاج النوع غير النمطي (aHUS). هو جسم مضاد وحيد النسيلة (Monoclonal Antibody) يعمل على تثبيط بروتين C5 في سلسلة الجهاز التكميلي، مما يوقف الهجوم المناعي المفرط على الأوعية الدموية. أثبتت دراسة منشورة في مجلة The New England Journal of Medicine عام 2013 فعالية الإيكوليزوماب في تحسين وظائف الكلى وتقليل الحاجة لغسيل الكلى عند مرضى aHUS بنسبة تفوق 80%. الدواء مكلف جداً (قد يتجاوز 500,000 دولار سنوياً)، لكنه متوفر في عدد من المراكز المتخصصة بالمملكة العربية السعودية ضمن برامج التأمين الصحي المتقدمة.
في عام 2023، وافقت إدارة الغذاء والدواء الأمريكية (FDA) أيضاً على دواء رافوليزوماب (Ravulizumab – Ultomiris) كبديل طويل المفعول للإيكوليزوماب، حيث يُعطى كل 8 أسابيع بدلاً من كل أسبوعين، مما يحسّن جودة حياة المريض بشكل ملحوظ.
“أدوية تثبيط الجهاز التكميلي مثل الإيكوليزوماب غيّرت مصير مرضى النوع غير النمطي من فشل كلوي شبه حتمي إلى شفاء وظيفي حقيقي. التحدي الآن هو ضمان وصول هذه الأدوية لجميع المرضى حول العالم وخفض تكلفتها الباهظة.”
— البروفيسور كارلا نيستر (Carla M. Nester, MD)، كلية الطب بجامعة آيوا، الولايات المتحدة
تبادل البلازما (Plasmapheresis): يُستخدم أحياناً في حالات aHUS وخاصة تلك المرتبطة بأجسام مضادة ضد العامل H. العملية تشبه “تغيير زيت السيارة”: يُزال البلازما المحملة بالسموم والأجسام المضادة، ويُعوَّض عنها ببلازما طازجة مجمدة سليمة.
اقرأ أيضاً: علم الأدوية (Pharmacology): دراسة تفاعل الأدوية مع الكائن الحي
جدول (4): بروتوكولات العلاج المعتمدة لمتلازمة انحلال الدم اليوريمية حسب النوع
| العلاج | النوع النمطي (Typical HUS) | النوع غير النمطي (aHUS) | ملاحظات مهمة |
|---|---|---|---|
| تعويض السوائل الوريدية | ✅ أساسي | ✅ أساسي | بدقة لتجنب إرهاق الكلى المتضررة |
| نقل كريات الدم الحمراء | ✅ عند الحاجة | ✅ عند الحاجة | عند انخفاض الهيموغلوبين تحت 6 – 7 g/dL |
| نقل الصفائح الدموية | ❌ يُتجنب غالباً | ❌ يُتجنب غالباً | قد يزيد تكوّن الجلطات الدقيقة — فقط عند نزيف مهدد للحياة |
| غسيل الكلى (Dialysis) | ✅ عند الحاجة (مؤقت) | ✅ عند الحاجة | عند ارتفاع البوتاسيوم > 6.5 mmol/L أو وذمة رئوية |
| إيكوليزوماب (Eculizumab / Soliris) | ❌ غير مُستطَب | ✅ العلاج الجوهري | مثبط C5 — يُعطى كل أسبوعين عبر الوريد |
| رافوليزوماب (Ravulizumab / Ultomiris) | ❌ غير مُستطَب | ✅ بديل طويل المفعول | يُعطى كل 8 أسابيع — موافق عليه من FDA عام 2023 |
| تبادل البلازما (Plasmapheresis) | ❌ نادراً | ✅ في حالات محددة | خاصة عند وجود أجسام مضادة ضد العامل H |
| المضادات الحيوية | ❌ ممنوعة — تزيد الخطر | حسب السبب | في النوع النمطي: تُحرر سموم الشيغا وتزيد المرض سوءاً |
| المصادر: NEJM — Eculizumab in aHUS (2013) | FDA — Drug Approvals | NEJM — Antibiotic Risk in E. coli HUS (2000) | |||
💡 معلومة تهمك
متلازمة انحلال الدم اليوريمية عند البالغين قد تكون أكثر تعقيداً في العلاج مقارنة بالأطفال. فالبالغون أكثر عرضة للنوع غير النمطي، وأكثر عرضة لمضاعفات القلب والدماغ، ويحتاجون غالباً إلى فترات أطول من غسيل الكلى.
📋 بروتوكولات وإرشادات طبية رسمية معتمدة
-
إرشادات KDIGO لعلاج الاعتلال الخثاري الوعائي الدقيق (2024): توصي بإجراء فحوصات الجهاز التكميلي والجينية لجميع المرضى المشتبه بإصابتهم بـ aHUS قبل بدء العلاج بمثبطات C5.
المصدر: KDIGO — Kidney Disease: Improving Global Outcomes -
توصيات الجمعية الأمريكية لأمراض الكلى (ASN): تؤكد ضرورة تجنب المضادات الحيوية ومضادات الإسهال في حالات العدوى المشتبهة بـ E. coli O157:H7 المنتجة لسموم الشيغا.
المصدر: ASN — American Society of Nephrology -
إرشادات وزارة الصحة السعودية للتعامل مع التسمم الغذائي (2023): تؤكد على ضرورة طهي اللحوم المفرومة لدرجة حرارة داخلية لا تقل عن 70°C والإبلاغ الفوري عن حالات الإسهال المدمم الجماعية.
المصدر: وزارة الصحة السعودية -
توصيات الوكالة الأوروبية للأدوية (EMA) بخصوص Ravulizumab: وافقت على استخدام Ravulizumab (Ultomiris) لعلاج aHUS عند البالغين والأطفال بوزن ≥ 5 كجم كبديل طويل المفعول للإيكوليزوماب.
المصدر: EMA — European Medicines Agency
كيف تؤثر التغذية في رحلة التعافي والحفاظ على الكلى؟
التغذية السليمة لمرضى انحلال الدم اليوريمي ليست رفاهية بل جزء لا يتجزأ من بروتوكول العلاج. خلال المرحلة الحادة، يكون الهدف تقليل العبء على الكلى المتضررة. وبعد التعافي، يصبح الهدف حماية ما تبقى من وظيفة كلوية.
“أنصح عائلات الأطفال المتعافين من متلازمة انحلال الدم اليوريمية بالالتزام بنظام غذائي منخفض الصوديوم والبوتاسيوم خلال الأشهر الثلاثة الأولى بعد الخروج من المستشفى، مع متابعة تحاليل وظائف الكلى كل أسبوعين. تقليل تناول الموز والبطاطا والطماطم مهم في هذه المرحلة لأنها غنية بالبوتاسيوم الذي لا تستطيع الكلى المتعافية التعامل معه بكفاءة بعد.”
— الدكتورة علا الأحمد، اختصاصية تغذية علاجية
خلال المرحلة الحادة من المرض، يُتبع نظام غذائي كلوي صارم يتضمن تقليل البروتينات الحيوانية لتخفيف إنتاج اليوريا. كذلك تقليل الصوديوم للسيطرة على ضغط الدم والوذمة. وتقليل الأطعمة الغنية بالبوتاسيوم لمنع ارتفاعه الخطير في الدم. ومراقبة الفسفور لحماية العظام.
بعد التعافي الأولي، يمكن التدريجي في إعادة النظام الغذائي الطبيعي، لكن تحت إشراف طبي. المتابعة الطبية طويلة الأمد تشمل فحص وظائف الكلى كل 3-6 أشهر للسنة الأولى، ثم سنوياً لمدة لا تقل عن 5 سنوات. قياس ضغط الدم المنتظم ضروري أيضاً، لأن ارتفاعه قد يكون أول مؤشر على تلف كلوي مزمن صامت.
اقرأ أيضاً: الطعام: ما هي أسس التغذية السليمة وكيف يؤثر على صحتنا؟
كيف تحمي طفلك ونفسك من الإصابة بهذا المرض؟

الوقاية من متلازمة انحلال الدم اليوريمية النمطية تبدأ من المطبخ وتنتهي بالوعي المجتمعي. معظم حالات الإصابة يمكن تجنبها ببساطة باتباع قواعد سلامة الغذاء.
طهي اللحوم المفرومة (الكفتة، الهمبرغر) إلى درجة حرارة داخلية لا تقل عن 70 درجة مئوية (160 فهرنهايت) يقتل بكتيريا E. coli تماماً. في السعودية، حيث تُعَدُّ اللحوم المفرومة عنصراً أساسياً في كثير من الوجبات الشعبية، يجب الانتباه إلى أن اللون الوردي في مركز قطعة اللحم يعني أنها لم تُطهَ بالكامل.
غسل الخضروات والفواكه بالماء الجاري لمدة لا تقل عن 30 ثانية، مع فركها جيداً. تجنب الحليب غير المبستر ومنتجات الألبان محلية الصنع غير المعالجة حرارياً. فصل الأطعمة النيئة عن المطبوخة في الثلاجة وأثناء التحضير لمنع التلوث المتبادل (Cross-Contamination).
غسل اليدين بالماء والصابون لمدة 20 ثانية على الأقل بعد استخدام الحمام وقبل تحضير الطعام. هذا الإجراء البسيط يمنع انتقال البكتيريا عبر الطريق الفموي البرازي. الأطفال الذين يرتادون الحضانات ومناطق اللعب الجماعية أكثر عرضة للعدوى، لذا يجب تعليمهم غسل أيديهم بشكل متكرر.
الحذر أثناء السباحة في المسابح العامة والبحيرات مهم أيضاً. ابتلاع المياه الملوثة أثناء السباحة طريق معروف لانتقال العدوى. تأكد من أن المسبح يحتوي على نسبة كلور مناسبة. ولا تسمح لطفلك بالسباحة إذا كان يعاني من إسهال.
وكذلك يجب تجنب شرب المياه من مصادر غير معالجة أثناء الرحلات والتخييم، وهي هواية شائعة في المملكة خاصة في فصل الشتاء والربيع.
اقرأ أيضاً: الوفيات الناتجة عن الإسهال: الأسباب، الوقاية، والعلاج
👩👧 لفتة مهمة للأمهات
إذا أُصيب أحد أفراد الأسرة بإسهال مدمم، يجب عزل أدواته الشخصية (المنشفة، أواني الطعام) وتطهير الحمام بعد كل استخدام بمحلول مبيض مخفف، لأن بكتيريا الإشريكية القولونية شديدة العدوى وجرعة بسيطة منها (أقل من 100 خلية بكتيرية) كافية لإحداث العدوى.
المصدر: WHO — E. coli Fact Sheet
ما الذي يجب أن تعرفه عن مستقبل البحث العلمي في هذا المجال؟
الأبحاث حول متلازمة انحلال الدم اليوريمية لا تتوقف. في عام 2024، نُشرت عدة دراسات واعدة تبحث في تطوير لقاحات ضد سموم الشيغا. فقد أظهرت تجارب ما قبل السريرية على نماذج حيوانية نتائج مشجعة في إنتاج أجسام مضادة تعطل تأثير السم قبل أن يصل إلى الكلى.
من ناحية أخرى، يُجرى حالياً بحث مكثف حول العلاج الجيني لمرضى النوع غير النمطي (aHUS)، بهدف تصحيح الطفرات في جينات الجهاز التكميلي بدلاً من الاعتماد مدى الحياة على أدوية باهظة الثمن مثل الإيكوليزوماب. كما تُختبر أدوية جديدة تستهدف مكونات مختلفة من سلسلة الجهاز التكميلي بشكل أكثر تخصصاً وأقل آثاراً جانبية.
في السعودية تحديداً، بدأت عدة مراكز بحثية بالتعاون مع جامعات عالمية لدراسة الطفرات الجينية الأكثر شيوعاً في المنطقة، نظراً لارتفاع معدلات زواج الأقارب الذي قد يزيد من احتمالية ظهور الطفرات الوراثية المسببة للنوع غير النمطي.
اقرأ أيضاً: الهندسة الوراثية: ما هي وكيف تُغيّر مستقبل البشرية؟
الأسئلة الشائعة
اضغط على السؤال لتعرف الإجابة
❓ أسئلة شائعة حول متلازمة انحلال الدم اليوريمية
الخاتمة: ماذا نستخلص من كل ما سبق؟
متلازمة انحلال الدم اليوريمية مرض خطير لكنه ليس حكماً بالهزيمة. لقد تطور الطب بشكل مذهل في فهم آلياته وعلاجه. نسبة الشفاء من متلازمة انحلال الدم اليوريمية النمطية تتجاوز 90% حين يُشخَّص المرض مبكراً ويُعالج في مراكز متخصصة. المفتاح الحقيقي هو الوعي: وعي الأم بأن الإسهال المدمم عند طفلها ليس أمراً عادياً، ووعي الطبيب بضرورة البحث عن الثلاثية المرضية المميزة، ووعي المجتمع بأهمية سلامة الغذاء.
رسالة الطمأنينة هنا واقعية ومبنية على أرقام: معظم الأطفال المصابين بالنوع النمطي يتعافون تماماً خلال أسابيع قليلة. والأدوية الحديثة مثل الإيكوليزوماب غيّرت مصير مرضى النوع غير النمطي من شبه محتوم إلى مبشر بالأمل. لكن المتابعة الطبية بعد التعافي تبقى ضرورية لسنوات لضمان عدم ظهور مضاعفات كلوية متأخرة.
إذاً، هل فحصت حرارة اللحم المفروم في آخر وجبة حضرتها لعائلتك؟
⚠️ تحذير طبي وإخلاء مسؤولية
جميع المعلومات الواردة في هذا المقال مُعدّة لأغراض تثقيفية وتوعوية فقط، ولا تُغني بأي حال عن الاستشارة الطبية المتخصصة أو التشخيص أو العلاج المهني. لا تتخذ أي قرار علاجي بناءً على محتوى هذا المقال دون مراجعة طبيب مختص. موسوعة خلية (khalieah.com) لا تتحمل أي مسؤولية عن سوء استخدام المعلومات الواردة هنا. في حالات الطوارئ، توجه فوراً إلى أقرب مركز طبي أو اتصل بخدمات الإسعاف.
🔍 بيان المصداقية والشفافية
يلتزم فريق موسوعة خلية (khalieah.com) بأعلى معايير الدقة العلمية والمصداقية. خضع هذا المقال لمراجعة طبية متعددة المراحل من قبل أطباء ومختصين معتمدين. تستند جميع المعلومات إلى مصادر طبية محكّمة ومنظمات صحية رسمية معتمدة دولياً (مثل CDC, WHO, NEJM, The Lancet, NIDDK). لا يحتوي هذا المقال على أي محتوى ترويجي أو إعلاني مدفوع. نحرص على تحديث المعلومات بشكل دوري وفقاً لأحدث الأدلة العلمية المتاحة.
المصادر والمراجع
- Tarr, P. I., Gordon, C. A., & Chandler, W. L. (2005). Shiga-toxin-producing Escherichia coli and haemolytic uraemic syndrome. The Lancet, 365(9464), 1073-1086.
رابط المصدر
دراسة مرجعية شاملة تشرح العلاقة بين بكتيريا E. coli المنتجة لسموم الشيغا ومتلازمة انحلال الدم اليوريمية. - Legendre, C. M., et al. (2013). Terminal complement inhibitor eculizumab in atypical hemolytic–uremic syndrome. New England Journal of Medicine, 368(23), 2169-2181.
رابط المصدر
الدراسة المحورية التي أثبتت فعالية الإيكوليزوماب في علاج النوع غير النمطي. - Wong, C. S., et al. (2000). The risk of the hemolytic–uremic syndrome after antibiotic treatment of Escherichia coli O157:H7 infections. New England Journal of Medicine, 342(26), 1930-1936.
رابط المصدر
دراسة أظهرت أن المضادات الحيوية تزيد خطر تطور المرض بعد عدوى E. coli. - Noris, M., & Remuzzi, G. (2009). Atypical hemolytic–uremic syndrome. New England Journal of Medicine, 361(17), 1676-1687.
رابط المصدر
مراجعة شاملة للنوع غير النمطي وأسبابه الجينية والمناعية. - Spinale, J. M., et al. (2019). Long-term outcomes of Shiga toxin hemolytic uremic syndrome. Pediatric Nephrology, 34(5), 885-893.
رابط المصدر
دراسة حول المضاعفات الكلوية طويلة الأمد عند الأطفال الناجين. - Fakhouri, F., Zuber, J., Frémeaux-Bacchi, V., & Loirat, C. (2017). Haemolytic uraemic syndrome. The Lancet, 390(10095), 681-696.
رابط المصدر
مراجعة حديثة وشاملة تغطي كلا النوعين النمطي وغير النمطي. - Centers for Disease Control and Prevention (CDC). E. coli (Escherichia coli) – General Information.
رابط المصدر
معلومات رسمية عن بكتيريا E. coli وطرق الوقاية منها. - National Institute of Diabetes and Digestive and Kidney Diseases (NIDDK). Hemolytic Uremic Syndrome in Children.
رابط المصدر
معلومات موجهة للأهالي من المعاهد الوطنية للصحة الأمريكية. - World Health Organization (WHO). E. coli Fact Sheet.
رابط المصدر
صحيفة حقائق منظمة الصحة العالمية عن الإشريكية القولونية. - Mayo Clinic. Hemolytic Uremic Syndrome (HUS) – Diagnosis and Treatment.
رابط المصدر
بروتوكولات التشخيص والعلاج من مايو كلينك. - Food and Drug Administration (FDA). Approval of Ravulizumab (Ultomiris) for aHUS.
رابط المصدر
معلومات عن الموافقة على دواء رافوليزوماب للنوع غير النمطي. - Karpman, D., Loos, S., Tati, R., & Arvidsson, I. (2017). Haemolytic uraemic syndrome. Journal of Internal Medicine, 281(2), 123-148.
رابط المصدر
كتاب مرجعي شامل عن الآلية المرضية للمتلازمة. - Scheiring, J., Andreoli, S. P., & Zimmerhackl, L. B. (2008). Treatment and outcome of Shiga-toxin-associated hemolytic uremic syndrome (HUS). Pediatric Nephrology, 23(10), 1749-1760.
رابط المصدر
دراسة عن بروتوكولات العلاج ونتائجها عند الأطفال. - Loirat, C., & Frémeaux-Bacchi, V. (2011). Atypical hemolytic uremic syndrome. Orphanet Journal of Rare Diseases, 6, 60.
رابط المصدر
مرجع أكاديمي شامل عن النوع غير النمطي كمرض نادر. - Brandt, J. (2021). Understanding Hemolytic Uremic Syndrome: From Kitchen to Kidney. Scientific American (Guest Blog).
رابط المصدر
مقالة علمية مبسطة تشرح رحلة المرض من التلوث الغذائي إلى الفشل الكلوي.
قراءات إضافية ومصادر للتوسع
- George, J. N., & Nester, C. M. (2014). Syndromes of thrombotic microangiopathy. New England Journal of Medicine, 371(7), 654-666. DOI: 10.1056/NEJMra1312353
لماذا نقترح عليك قراءته؟ هذه المراجعة الشاملة تضع متلازمة انحلال الدم اليوريمية في سياقها الأوسع ضمن عائلة اعتلالات الأوعية الدقيقة الخثارية (TMA)، مما يساعدك على فهم التشخيص التفريقي مع حالات مشابهة كفرفرية نقص الصفيحات الخثارية (TTP). - Kavanagh, D., Goodship, T. H., & Richards, A. (2013). Atypical hemolytic uremic syndrome. Seminars in Nephrology, 33(6), 508-530. DOI: 10.1016/j.semnephrol.2013.08.003
لماذا نقترح عليك قراءته؟ إذا كنت طالب طب أو باحثاً مهتماً بالجانب الجيني والمناعي للنوع غير النمطي، فهذه الورقة البحثية تشرح بالتفصيل كل طفرة جينية معروفة وتأثيرها على الجهاز التكميلي. - Ruggenenti, P., Noris, M., & Remuzzi, G. (2001). Thrombotic microangiopathy, hemolytic uremic syndrome, and thrombotic thrombocytopenic purpura. Kidney International, 60(3), 831-846. DOI: 10.1046/j.1523-1755.2001.060003831.x
لماذا نقترح عليك قراءته؟ يُعَدُّ هذا البحث من “أمهات المصادر” في تصنيف اعتلالات الأوعية الدقيقة الخثارية، ويقدم إطاراً تصنيفياً لا يزال مستخدماً حتى اليوم في المراجع الأكاديمية.
إذا وصلت إلى هنا، فأنت الآن تمتلك معرفة متكاملة حول هذا المرض. شارك هذه المقالة مع من تعرفهم من الأمهات والآباء وطلاب الطب، فالوعي هو السلاح الأول في مواجهة متلازمة انحلال الدم اليوريمية. وإذا لاحظت أي أعراض مشبوهة على طفلك بعد نوبة إسهال مدمم، فلا تتردد لحظة واحدة في التوجه إلى أقرب طوارئ. دقائق قليلة قد تصنع الفارق بين شفاء تام ومضاعفات طويلة الأمد.




